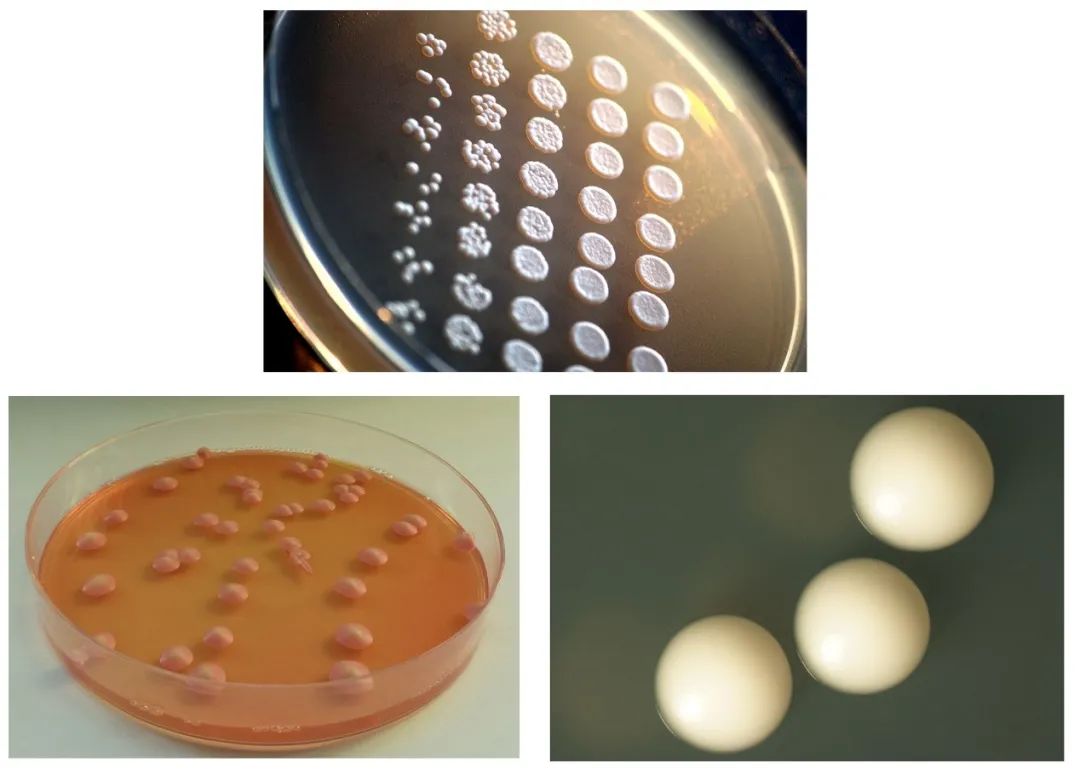

- +1
五千年前埃及人钟爱的灌装啤酒,是个啥味道?
原创 Eevee 我是科学家iScientist
逢年过节,亲朋相聚,啤酒总是宴席上不可或缺的助兴饮品,在世界各国都广受欢迎。埃及作为啤酒的发源地之一,5000多年前就熟练掌握了酿造啤酒的手艺,留下不少与啤酒有关的历史记录。
 公元前1350的古埃及人用吸管享用啤酒的壁画 | Staatliche Museen zu Berlin
公元前1350的古埃及人用吸管享用啤酒的壁画 | Staatliche Museen zu Berlin那么,这五千年前的啤酒究竟是个什么味道?今天的人们还有没有机会再一品当年的佳酿?
这个可以有!
打开古老佳酿的钥匙:酵母
一群来自以色列的科学家打开了一道通往古埃及传送门。
而钥匙就是藏在古埃及酒坛子里的酵母[1]。
酵母,是一类真菌。也正是酿造啤酒的灵魂所在——虽然古代人无法窥见它的真容,它却早就融入人类的生活。除了啤酒,馒头、面包、葡萄酒等等都是酵母们的杰作。
酵母,名如其名,是“发酵之母”,经常用来泛指酵母亚门Saccharomycotina的各种真菌,不过最为经典的便是用来发酵啤酒、面包酿酒酵母(Saccharomyces cerevisiae)(左);给红酒带去复杂滋味的酒香酵母(Brettanomyces spp.)(左下),以及引起人类疾病(鹅口疮)的白色念珠菌(Candida albicans)(右下) | Wikimedia Commons, Rainis Venta, CC BY-SA 3.0 / https://creativecommons.org/licenses/by-sa/3.0 & Wikimedia Commons, Bojan Žunar, CC BY-SA 4.0 / https://creativecommons.org/licenses/by-sa/4.0 &参考文献 [4]
酵母,名如其名,是“发酵之母”,经常用来泛指酵母亚门Saccharomycotina的各种真菌,不过最为经典的便是用来发酵啤酒、面包酿酒酵母(Saccharomyces cerevisiae)(左);给红酒带去复杂滋味的酒香酵母(Brettanomyces spp.)(左下),以及引起人类疾病(鹅口疮)的白色念珠菌(Candida albicans)(右下) | Wikimedia Commons, Rainis Venta, CC BY-SA 3.0 / https://creativecommons.org/licenses/by-sa/3.0 & Wikimedia Commons, Bojan Žunar, CC BY-SA 4.0 / https://creativecommons.org/licenses/by-sa/4.0 &参考文献 [4]古埃及的酒坛由陶土烧制而成,里面往往有很多孔隙。盛装啤酒后会有少量酵母渗透入这些孔隙之中,久而久之这些酵母就被永远“封印”在了这些酒坛里。
为了看看这些坛子能否保存酵母,科学家们做了一个细致的预实验:先将几个陶罐分别盛装不含酵母的啤酒(经过滤灭菌)和包含酵母的啤酒,然后就地挖坑活埋3个月再来探个究竟。结果发现,只有在装了包含酵母的啤酒坛子里,可以再次分离得到同种酵母,猜想得到了证实。
 陶罐孔隙中酵母的扫描电镜照片 | 参考文献[1]
陶罐孔隙中酵母的扫描电镜照片 | 参考文献[1]然而问题来了,保存几个月、几年不算啥,时隔5000多年,酿酒酵母还有可能还活下来吗?这可就不好说了,此前复活啤酒酵母的最高纪录是间隔166年,有人在英国岸边的一艘沉船里成功活复活了于1825年产的啤酒瓶中的酵母[2]。
 这款百年老酵母酿出的啤酒,曾经卖得还不错| Brewlab.co.uk
这款百年老酵母酿出的啤酒,曾经卖得还不错| Brewlab.co.uk不过,一个多世纪和5000多年相比好像还是相差甚远。别担心,像酵母这样的真菌,有着无限的潜力——一位日本科学家在群马县藤冈市距离地表600-3000米的中新世(距今2400万年)土层中就成功复活过包括曲霉、木霉、青霉在内的多种真菌,其中就有一种古老的酵母[3]。有了这个记录做保底,科学家还是有些底气了。接下来,就去找(砸)酵(古)母(董)吧!
大型干尸复活现场
以色列地处古代啤酒酿造最为盛行的地区,也是最容易出土古代酒坛子的地方。这里可以找到大流士一世在位时波斯帝国的日常用啤酒坛(公元前500年),还能找到海上移民部落腓力斯丁(Philistine)人所用的酒器,以及古埃及第一王朝时期的酒器。
 中东十字路口以色列,啥宝贝都有!| 参考文献[1]
中东十字路口以色列,啥宝贝都有!| 参考文献[1]找到了古董,就可以愉快地开砸了(才怪)。科学家们循着瓶罐上的一些裂缝小心地剥离一些碎片,加入麦汁(培养基)让沉睡千年的酵母干尸们先泡个营养澡,顺带呼吸一下21世纪的新鲜空气。沉睡在陶片中的不仅仅有酵母,还有各类复杂的微生物,还需要通过酵母选择培养基筛选,最后通过基因检测的最终考验,就这样,沉睡于陶片缝隙中的酵母就能重见天日!
 并不复杂的复活流程 | 参考文献[1]
并不复杂的复活流程 | 参考文献[1]然而,事情并没有这么简单。还有一个非常重要的问题不能忽略:如何佐证这些酵母确实是来源陶片本身,而不是来源于周围的复杂土壤环境呢?这就得通过考察更多的文物来验证了。
 事情当然也不是这么简单 | 《游戏王》剧照
事情当然也不是这么简单 | 《游戏王》剧照生物考古学家们随手拿来了27件和啤酒不相关的“锅碗瓢盆”,比如古埃及的“洗脚盆”“火锅”“水瓢”等等,53份考古发掘点周围的石头,以及30份和考古点不相关的石头。又是一顿麦汁泡澡分离选择,然而仅得到了2种和发酵不相关的酵母(包括白色念珠菌和一种植物上的野生酵母)。看来,只有装过上古啤酒的陶罐才是打开传送门正解,环境中的一些酵母无法影响到实验。
 腓力斯丁人所使用的啤酒陶罐 | Wikimedia Commons, Hanay, CC BY-SA 3.0 / https://creativecommons.org/licenses/by-sa/3.0
腓力斯丁人所使用的啤酒陶罐 | Wikimedia Commons, Hanay, CC BY-SA 3.0 / https://creativecommons.org/licenses/by-sa/3.0盘了不少古玩之后,总算吹尽狂沙始到金,6位木乃伊酿酒酵母“破棺而起”,我们真的可以用先民的酵母酿酒啦!
 6种“复活”的酵母 | 作者根据参考文献[1]重置
6种“复活”的酵母 | 作者根据参考文献[1]重置古代酿酒酵母的终极酿造对决!
修复完文物的科学家们,紧接着投入到酿酒工作中。不同的酿酒酵母在相同的原料、水质、发酵温度等条件下,会呈现绝然不同的感官体验,至于哪款的口味最好,就得请专业人士来品鉴了。
以下是他们给出的评分,可见,各款古代酵母都有出色的表现力,和目前的商用酵母不分伯仲。
 根据BJCP(Beer Judge Certification Program)评委对“复活”酵母和商用酵母所酿造啤酒的风味表现的打分情况(分值越高代表该风味越突出) | 参考文献[1]
根据BJCP(Beer Judge Certification Program)评委对“复活”酵母和商用酵母所酿造啤酒的风味表现的打分情况(分值越高代表该风味越突出) | 参考文献[1]其实在此之前,众多酒厂一直在孜孜不倦地尝试复原古代啤酒。譬如擅长开拓新技法的美国酒厂角头鲨,就曾经复原过所谓古埃及配方的啤酒,还也复原了世界历史上最早的酒——贾湖;比利时Dupont酒厂更是出品过一款古罗马帝国时期高卢地区配方的啤酒Posca Rustica;荷兰Jopen酒厂复原过啤酒花使用前中世纪最为流行的格鲁特啤酒。
 各大酒厂复原传说中的啤酒的脚步不曾停歇,类似贾湖一度被认为是世界上最古老的酒而广受青睐(高大师+角头鲨)包括之前5000年前的米家崖中国啤酒也已经问世(京A)传送门:https://mp.weixin.qq.com/s/I1oroVSLwwTosJ8XWNuWtA | 图片来自各啤酒品牌的官方网站
各大酒厂复原传说中的啤酒的脚步不曾停歇,类似贾湖一度被认为是世界上最古老的酒而广受青睐(高大师+角头鲨)包括之前5000年前的米家崖中国啤酒也已经问世(京A)传送门:https://mp.weixin.qq.com/s/I1oroVSLwwTosJ8XWNuWtA | 图片来自各啤酒品牌的官方网站但上述的种种“古代”啤酒完完全全是现代的产物,不论从酿造的器具、环境以及原料,都融入了现代的技术,就算用上同款的陶罐,来自当地的原料并就地酿造,也和当年的啤酒滋味不尽相同。而最关键是酿酒的灵魂——酵母已经和当时不尽相同,这样的复原,必然是大打折扣的。
不得不说,以色列生物考古的科学家们真正意义上复活了中东地区的初代酿酒酵母(秽土转生的那种),将一小部分5000年前古埃及人“随缘”筛选出的酿酒酵母展现在我们面前。
虽然水质、发酵温度、原料品质、制作工艺等等方面都会影响啤酒的味道,现代人未必能复原出和古埃及同款的“罐装啤酒”,但这项研究工作,无疑刷新了我们对酿酒酵母的认知,更让我们有了和古代酿酒师同场竞技的机会。
兴许,不久之后,我们就能品尝到这些穿越时空的佳酿了。
最后还要温馨提醒大家,佳酿虽美但多饮伤身,切勿贪杯啊!
作者名片
 作者:Eevee
作者:Eevee编辑:Yuki
排版:夏晓茜
题图:Staatliche Museen zu Berlin
参考文献:
[1] Aouizerat, T., Gutman, I., Paz, Y. et al., 2019. Isolation and Characterization of Live Yeast Cells from Ancient Vessels as a Tool in Bio-Archaeology. mBio 10, e00388-19.
[2] Coghlan, A. 1991. The beer that came back from the deep. New Science 131(1786), 4.
[3] Sugiyama, J. & Goto, S. 1969. Mycoflora in core samples from stratigraphic drillings in middle Japan. IV. The yeast genera Candida Berkhout, Trichosporon Behrend, and Rhodotorula Harrison em. Lodder from core samples. Journal of the Faculty of Science. Univerisity of Tokyo III 10, 97-118.
[4] Zhou, X. & Li, Y. 2015, Chapter 5 - Oral Mucosal Microbes. Atlas of Oral Microbiology, 95-107.
欢迎个人转发到朋友圈
本文版权属于“我是科学家”,未经授权不得转载。如需转载请联系iscientist@guokr.com
原标题:《五千年前埃及人钟爱的灌装啤酒,是个啥味道?》
本文为澎湃号作者或机构在澎湃新闻上传并发布,仅代表该作者或机构观点,不代表澎湃新闻的观点或立场,澎湃新闻仅提供信息发布平台。申请澎湃号请用电脑访问http://renzheng.thepaper.cn。





- 报料热线: 021-962866
- 报料邮箱: news@thepaper.cn
互联网新闻信息服务许可证:31120170006
增值电信业务经营许可证:沪B2-2017116
© 2014-2026 上海东方报业有限公司




